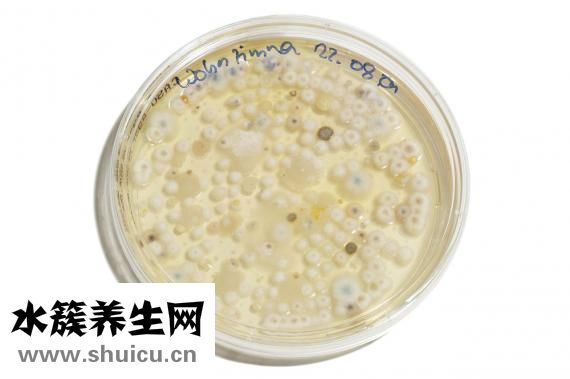

引火湯在一定程度上是可以清熱解毒的,而且因?yàn)橐饻?dāng)中有一定的雜質(zhì),所以說在調(diào)養(yǎng)身體的時(shí)候可以適當(dāng)?shù)暮纫恍梢郧鍩峤舛荆€能夠去除痘印,也是比較常見的一種保健湯,引火湯的制作方法也比較簡單,可以準(zhǔn)備些綠豆,適當(dāng)?shù)氖萑夂屠苯罚瑴?zhǔn)備適量的水,就可以來了。

材料:綠豆,綠豆100g,薏苡仁150g,瘦肉100g,黃豆(或黃豆)100g,生姜,紅糖適量。

1.綠豆提前半天浸泡,或用冷水泡1個(gè)小時(shí),或用冷水泡1個(gè)小時(shí)。
2.瘦肉切塊,黃豆,生姜切絲。
3.所有材料放進(jìn)鍋里加適量的水。
4.煮半個(gè)小時(shí),加紅糖調(diào)味即可。

1.綠豆清洗干凈,提前一晚泡發(fā),等再泡一夜。
2.排骨斬大塊,冷水入鍋,大火煮開。
3.焯掉血水。
4.把豬大腸切小塊。
5.熱油鍋,把排骨煸炒。
6.放入紅糖。
7.炒到排骨變色,微焦。
8.放入綠豆,翻炒。
9.倒入開水。
10.放入料酒。
11.放入生姜。
12.放入少許食鹽。

13.大火燒開,小火燉1個(gè)半小時(shí)左右,放入少量味精,即可。
引火湯的做法是十分簡單。
水蘿卜是一種價(jià)廉物美的蔬菜水果,而且也具備一定的服用使用價(jià)值,因而,因?yàn)樗质艽蠹业南矏邸?墒牵谄匠#}卜的恰當(dāng)作法是有很多的,不一樣的做法,具備不一樣的營養(yǎng)成分作用,這種作法能夠讓大家的水...

綠茶大家都不陌生,綠茶是很常見的飲品,對這樣飲品在喝的時(shí)候,完全是可以放心進(jìn)行,綠茶在口感上是非常獨(dú)特,不過在喝綠茶的時(shí)候,也是要適量,很多人在喝綠茶的時(shí)候,都是喜歡放一些糖和糖,這樣在喝的時(shí)候,對身...

打噴涕流鼻涕是比較普遍的,當(dāng)碰到比較嚴(yán)重的感冒癥狀時(shí),非常容易流鼻涕,當(dāng)出現(xiàn)打噴涕流鼻水的狀況時(shí),要警醒有發(fā)燒感冒,也是有一部分病人會在近幾天或是是幾個(gè)星期以內(nèi),因?yàn)樘鞖飧稍铮蚴鞘潜徊【腥镜?..

海帶是一種營養(yǎng)價(jià)值比較高的食物,它含有豐富的碘,在人體獲取碘元素,具有提高免疫力、抗腫瘤等作用。如果處于生理期,適當(dāng)吃一些海帶,對身體健康是有好處的,當(dāng)然,在生理期吃海帶是會造成一定的影響的,所以...

原位癌,別名癌,包含胃癌、直腸癌、胰腺癌、腦部腫瘤,在其中以子宮頸癌、直腸癌更加普遍。大部分原位癌是產(chǎn)生在腋下、腹部、陰道內(nèi)、女性陰道或腸胃位置,臨床醫(yī)學(xué)關(guān)鍵為病理學(xué)種類。腫瘤的生長發(fā)育速...

仙草對于醫(yī)藥方面的價(jià)值是我們難以想象的,對于治療一些疾病是很有效的。仙草中含有很多對人體有益的物質(zhì),我們一起來看一看。

女士每個(gè)月必須來一次經(jīng)期,在這段時(shí)間里經(jīng)期是女士每個(gè)月都是親身經(jīng)歷的,可是也是有一些女士可能出現(xiàn)了腰疼的病癥,造成腰疼的原因比較多,比如腎虛、氣血兩虛、孑宮生長發(fā)育出現(xiàn)異常、孑宮腫瘤、內(nèi)分...

油醋汁什么味道?油醋汁是一種常見的口味飲品,油醋汁顧名思義就是用來加入不同的調(diào)料的,如海鮮醬油、辣椒醬等,油醋汁有很多口味,可以添加很多的食材,色香味俱全,味道不同,選擇油醋汁的時(shí)候,不同的味道有些...

眼周的身心健康是我們?nèi)孔非竺利愓叨夹枰P(guān)心的問題,由于眼周的身心健康會影響到全部五官的總體融洽水平。如今的生活壓力越來越大,人的身體脆化速率變的很快,這促使很多人都覺得雙眼會出現(xiàn)一定的...

咸鴨蛋在市面上是較為普遍的一種特色小吃,其味兒香甜,遭受很多人的喜愛,鴨蛋味兒也是十分非常好的,備受很多人的鐘愛,可是鴨蛋中因?yàn)閹в泻芏嗟柠}份,因而一些人針對咸鴨蛋味兒也并并不是很掌握,下邊就要...

硒是人體的生命之火,是人體內(nèi)不可缺少的營養(yǎng)成分,生活中很多水果都含有硒元素,但你知道含硒第一名的水果是什么嗎?含硒高的水果又有哪些呢?跟水簇養(yǎng)生網(wǎng)一起來看看吧。...

一級夫妻性生活的年紀(jì)大概在20歲到50歲左右,如果是一種比較好的情況下,性生活的頻率一般在10到20分鐘左右,如果是比較差的夫妻,性生活的頻率可能會受到很多因素的影響,有些人可能會擔(dān)心,性生活的質(zhì)量不...

黃ba等中草藥可用于治療多種男科疾病。 可是不應(yīng)過多使用。 畢竟,該藥具有三點(diǎn)毒性,并且肯定會引起身體某些副作用,尤其是對腎功能的影響,將產(chǎn)生非常大的影響,因此一定應(yīng)該引起注意, 可能會繼續(xù)導(dǎo)致自...

三道鱗魚是歐美鯽魚的一種變異魚,它在人體表面的鱗片很大。所以在歐洲的一些地區(qū),經(jīng)常有人用三道鱗魚來曬蝦米作為鏡子,所以三道鱗魚也有另外一個(gè)名字,鏡魚。如今,三道鱗魚已經(jīng)被引入中國許多地區(qū)進(jìn)行...

在我們的日常生活中,桂花酒屬于一種常見的酒,具有桂花樹的香味和多種營養(yǎng)元素,特別適合冬季飲用。桂花酒可以暖身祛寒作用,還可以合理減少疲勞功效,改善睡眠質(zhì)量等。...

許多人喜歡在冬天去釣魚。在這種情況下,米酒通常被用作巢的材料。對于一些更有經(jīng)驗(yàn)的人來說,筑巢是非常好的。然而,許多人沒有做好并死去。死亡巢穴的出現(xiàn)有很多原因。可能是制作巢料時(shí)香料的味道太...

三角肌 注射是預(yù)防接種醫(yī)院門診的重點(diǎn)工作。精確定位和選擇合適的位置對于確保安全注射非常重要。三角肌注射/的正確方式是什么?三角肌宜注射方法是將右手收緊在部分皮膚上,將無名指固定在針上,使針...

我堅(jiān)信很多人都吃過馬鮫魚,這是一種有價(jià)值的魚,營養(yǎng)含量很高,比如蛋白質(zhì)豐富多彩。另外,馬鮫魚含有維生素A和各種礦物質(zhì)元素。據(jù)了解,食用馬鮫魚具有補(bǔ)氣養(yǎng)血的功效,還具有止咳化痰的功效。女性可以通...

夏天很多人喜歡買泥鰍吃。泥鰍有很多做法,比如蒸、炸等等。它是一種人們非常喜歡吃的食物。而且泥鰍的營養(yǎng)價(jià)值也很高,但是每次吃的時(shí)候處理掉泥鰍是個(gè)麻煩的問題,尤其是如果內(nèi)臟需要清理的話。所以...

相信很多人都用過上海藥皂,它是中國上海第一塊特效除菌皂,那么上海藥皂都有什么作用呢?下面就來說說上海藥皂的功效與作用,一起來了解下吧。...


醫(yī)藥學(xué)上稱之為手肘穴位坐落于手臂內(nèi)側(cè)的特定位置



引火湯的配方(陳士鐸引火湯標(biāo)準(zhǔn)配方)




